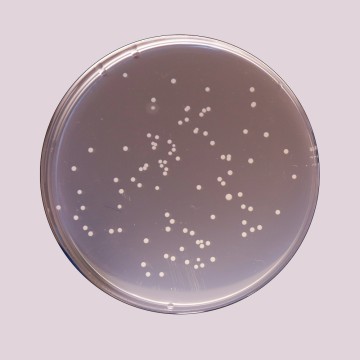
Plate Count Agar, Granulated  (Standard Methods Agar, Granulated)
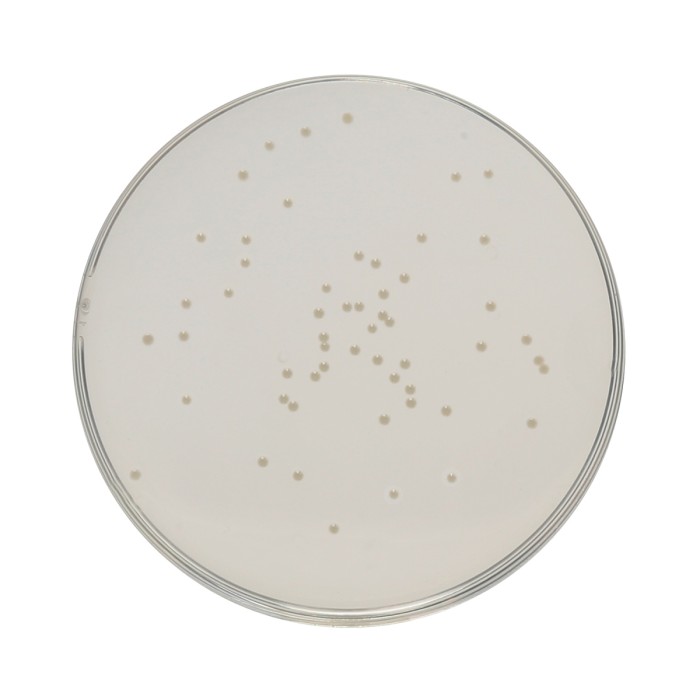
HiEncap™ Plate Count Agar (HiEncap™ Standard Methods Agar)

Your enquiry has been submitted
HiEncap™ Plate Count Agar (HiEncap™ Standard Methods Agar)
Intended Use:
Recommended for determination of plate counts of microorganisms in food, water and wastewater and clinical samples.
Composition**
| Ingredients | Gms/Litre |
|---|---|
| Tryptone | 5.000 |
| Yeast extract | 2.500 |
| Dextrose (Glucose) | 1.000 |
| Agar | 15.000 |
| Final pH (at 25°C) | 7.0±0.2 |
**Formula adjusted, standardized to suit performance parameters
Directions
Each capsule contains 11.75 gms of medium. Suspend 1 capsule in 500 ml (2 capsules in 1000 ml) distilled or purified water. Heat to boiling to dissolve the medium completely. Sterilize by autoclaving at 15 lbs pressure (121°C) for 15 minutes. Mix well and pour into sterile Petri plates.
Principle And Interpretation
Plate Count Agar is formulated as described by Buchbinder et al (2) which is recommended by APHA (1,6,7) and FDA (3). Tryptone provides amino acids and other complex nitrogenous substances. Yeast extract supplies Vitamin B complex. APHA recommends the use of pour plate technique. The samples are diluted and appropriate dilutions are added in Petri plates. Sterile molten agar is added to these plates and plates are rotated gently to ensure uniform mixing of the sample with agar. The poured plate count method is preferred to the surface inoculation method, since it gives higher results. Plate Count Agar is also suitable for enumerating bacterial count of sterile rooms.
Type of specimen
Clinical samples; Food and dairy samples; Water samples
Specimen Collection and Handling:
For clinical samples follow appropriate techniques for handling specimens as per established guidelines (4.5). For food and dairy samples, follow appropriate techniques for sample collection and processing as per guidelines (6,7). For water samples, follow appropriate techniques for sample collection, processing as per guidelines and local standards (1). After use, contaminated materials must be sterilized by autoclaving before discarding.
Warning and Precautions :
In Vitro diagnostic Use. Read the label before opening the container. Wear protective gloves/protective clothing/eye protection/face protection. Follow good microbiological lab practices while handling specimens and culture. Standard precautions as per established guidelines should be followed while handling clinical specimens. Safety guidelines may be referred in individual safety data sheets
Limitations :
- This medium is general purpose medium and may not support the growth of fastidious organisms.
Performance and Evaluation
Performance of the medium is expected when used as per the direction on the label within the expiry period when stored at recommended temperature.
Quality Control
Appearance
Gelatin capsule containing cream to yellow coloured granulated media.
Gelling
Firm, comparable with 1.5% Agar gel
Colour and Clarity of prepared medium
Light yellow coloured clear to slightly opalescent gel forms in Petri plates
Quantity
Each capsule contains 11.75 grams of medium sufficient for 500 ml media
Reaction
Reaction of 2.35% w/v aqueous solution at 25°C. pH: 7.0±0.2
pH
6.80-7.20
Cultural Response
Cultural characteristics observed after an incubation at 35 - 37°C for 18 - 48 hours.
| Organism | Growth | Inoculum (CFU) | Recovery |
|---|---|---|---|
| Lactobacillus casei ATCC 9595 | luxuriant | 50-100 | >=70% |
| Staphylococcus aureus subsp. aureus ATCC 25923 (00034*) | luxuriant | 50-100 | >=70% |
| Streptococcus pyogenes ATCC 19615 | luxuriant | 50-100 | >=70% |
| Bacillus subtilis subsp. spizizenii ATCC 6633 (00003*) | luxuriant | 50-100 | >=70% |
| Enterococcus faecalis ATCC 29212 (00087*) | luxuriant | 50-100 | >=70% |
| Escherichia coli ATCC 25922 (00013*) | luxuriant | 50-100 | >=70% |
Key: *Corresponding WDCM numbers.
Storage and Shelf Life
Store between 10-30°C in a tightly closed container and the prepared medium at 20-30°C. Use before expiry date on the label. On opening, product should be properly stored dry, after tightly capping the bottle inorder to prevent lump formation due to the hygroscopic nature of the product. Improper storage of the product may lead to lump formation. Store in dry ventilated area protected from extremes of temperature and sources of ignition. Seal the container tightly after use. Product performance is best if used within stated expiry period.
Disposal
User must ensure safe disposal by autoclaving and/or incineration of used or unusable preparations of this product. Follow established laboratory procedures in disposing of infectious materials and material that comes into contact with clinical sample must be decontaminated and disposed of in accordance with current laboratory techniques (4,5).
| Product Name | HiEncap™ Plate Count Agar (HiEncap™ Standard Methods Agar) |
|---|---|
| SKU | EC091D |
| Application/ Industry | Clinical, Food, Dairy, Water |
| Product Type | HiEncap™ |
| Physical Form | Granulated Media in Gelatin Capsule |
| Origin | Animal |
| Packaging type | HDPE Jar |
| References | 1. Buchbinder L., Baris Y., Aldd E., Reynolds E., Dilon E., Pessin V., Pincas L. and Strauss A., 1951, Publ. Hlth. Rep., 66:327. 2. Wehr H. M. and Frank J. H., 2004, Standard Methods for the Microbiological Examination of Dairy Products, 17th Ed., APHA Inc., Washington, D.C. 3. Downes F. P. and Ito K., (Eds.), 2001, Compendium of Methods for the Microbiological Examination of Foods, 4th Ed., APHA, Washington, D.C. 4. Eaton A. D., Clesceri L. S. and Greenberg A. E., Rice E. W., (Eds.), 2005, Standard Methods for the Examination of Water and Wastewater, 21st Ed., APHA, Washington, D.C.5.FDA Bacteriological Analytical Manual, 2005, 18th Ed., AOAC, Washington, DC. |